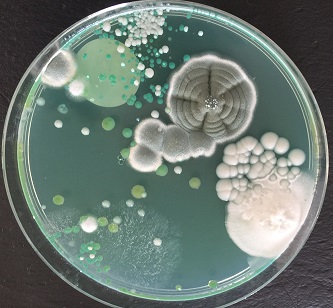

Formation professionnelle continue
Depuis son siège social à Toulouse, Action First organise des sessions interentreprises dans la France entière pour rapprocher la formation professionnelle de vos besoins. Des formations personnalisées ou en petits groupes pour atteindre vos objectifs et obtenir de meilleurs résultats.
Vous souhaitez organiser une session de formation dans vos locaux, n’importe où en France ? Contactez-nous et nous étudierons ensemble votre besoin pour vous proposer une solution adaptée.

Bonnes Pratiques de Laboratoire (BPL)
Code : F7T10A

Chimie verte et économie circulaire
Code : F7T10B

Norme ISO 9001 appliquée aux laboratoires chimiques
Code : F7T10C

Sécurité en laboratoire chimique
Code : F7T10D

Initiation à la génétique médicale pour les non-généticiens
Code : F7T10G
Technique de base en Microbiologie Alimentaire
Code : F7T11A

Bases de microbiologie alimentaire en laboratoire - Préparation des prises d'essai et mise en analyse
Code : F7T11B

Pathogènes alimentaires, maîtrise et analyse microbiologique
Code : F7T11C

Gestion de crise dans les laboratoires d'Analyses Microbiologiques et Biochimiques
Code : F7T11D

Validation de méthodes d’analyse en laboratoire : normes, performances et conformité
Code : F7T11H

Bonnes Pratiques de Laboratoire (BPL/GLP)
Code : F7T11I

Gestion du système documentaire en laboratoire
Code : F7T11J

Réglementation cosmétique européenne (CE 1223/2009) : obligations pour les laboratoires
Code : F7T11K

Culture cellulaire et bioproduction
Code : F7T11L

Gestion des risques en laboratoire
Code : F7T11N

Allergènes et étiquetage nutritionnel
Code : F7T11R

Les bases de la bactériologie
Code : F7T11T

Découverte des Techniques de Purification et de Séparation
Code : F7T11V

Microbiologie industrielle : méthodes de contrôle et maîtrise du risque microbiologique
Code : F7T12A

Bioproduction : fermenteurs et procédés upstream
Code : F7T12B

La prise d'essai et les dilutions des produits en vue de leur analyse microbiologique
Code : F7T11E

Challenge Test et Détection des biomolécules dans le secteur Pharmaceutique et Cosmétologie
Code : F7T11F
Données établies pour l'année 2025
Avantages
de réussite aux examens
de satisfaction client
de satisfaction sur la qualité pédagogique
de satisfaction sur la qualité des contenus
d’expérience
de formation
©2026 actionfirst.fr - Centre de formation professionnelle continue enregistré sous le numéro 73 31 02860 31 auprès du préfet de la région Occitanie.
Cet enregistrement ne vaut pas agrément de l'État. Mentions légales (0.035 s.)


J'accède ou je crée mon espace
Centre de formation professionnelle continue enregistré sous le numéro 73 31 02860 31